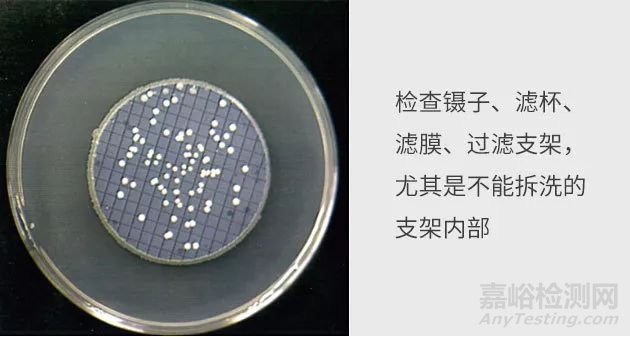
制藥用水微生物檢測中的常見問題
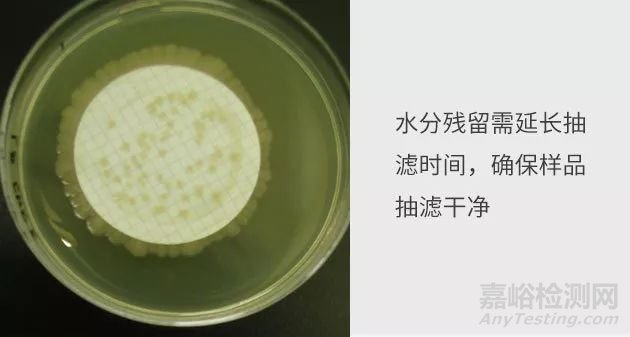
制藥用水微生物檢測中的常見問題
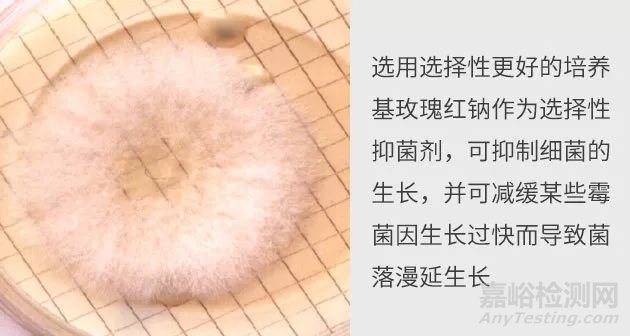
制藥用水微生物檢測中的常見問題
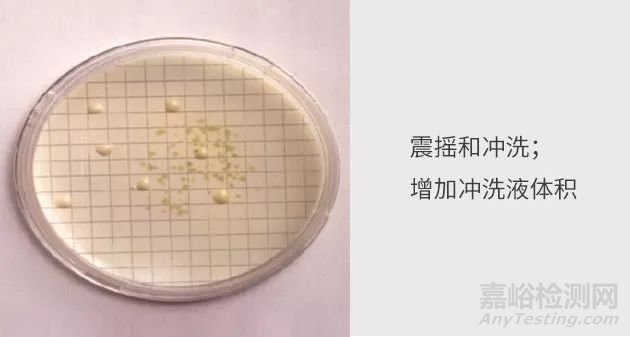
制藥用水微生物檢測中的常見問題
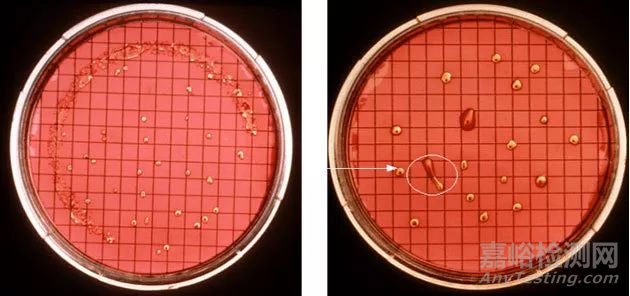
制藥用水微生物檢測中的常見問題

您當(dāng)前的位置:檢測資訊 > 實(shí)驗(yàn)管理
嘉峪檢測網(wǎng) 2018-01-31 09:38
在藥品生產(chǎn)中,由于受到各種因素(生產(chǎn)環(huán)境、空氣、制藥用水、人員操作、物料、設(shè)備等)的影響,都可能導(dǎo)致藥品的微生物污染。因此,GMP對(duì)這些因素都提出了防止污染的基本要求,其中,制藥用水是藥品生產(chǎn)過程中用量最大、應(yīng)用最廣泛的原料之一,主要用于生產(chǎn)過程和藥物制劑的制備,其微生物水平是很重要的質(zhì)控指標(biāo),直接關(guān)系到藥品的品質(zhì)。
制藥用水在純化、貯存和使用過程中,很容易受到微生物和其代謝產(chǎn)物的污染,影響藥品的質(zhì)量,引起不良的后果。因此,我們總結(jié)了在制藥用水微生物檢測中的一些常見現(xiàn)象和分析,和大家一起分享我們在實(shí)驗(yàn)操作中常見的問題和解決方法。
影響試驗(yàn)結(jié)果的因素:
常見的計(jì)數(shù)異常情況和原因分析:
1、滅菌不完全:
2、菌落蔓延和水分殘留:
3、膜下方長菌:
4、TNTC多不可計(jì):
5、真菌過度生長:
6、菌落分配不均勻:
7、濾杯受到污染: 8、濾膜表面有異物:
微生物不生長或生長不良的解決方法:
總 結(jié)
因此,選用選擇性更好的培養(yǎng)基,使用潔凈、無菌的過濾設(shè)備和實(shí)驗(yàn)耗材,規(guī)范實(shí)驗(yàn)操作,正確地在培養(yǎng)基上貼合濾膜,可有效地避免微生物不生長或生長不良的情況;在實(shí)驗(yàn)中,充分地混勻樣品和沖洗濾膜,增加沖洗液的體積,可有效地解決菌落分布不平均和消除樣品中抑菌物質(zhì)的作用。

驗(yàn)室經(jīng)理人.jpg)
來源:許亞威